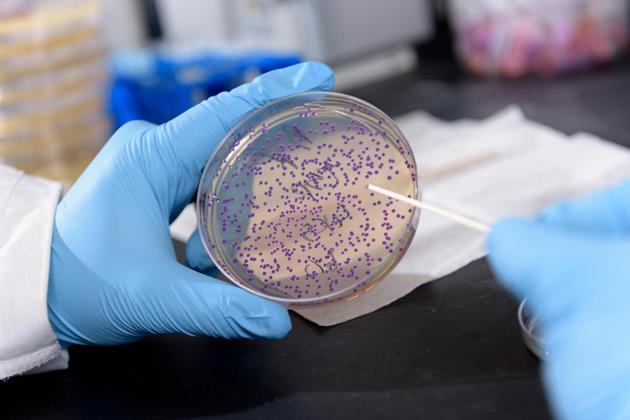
blood deficiency zinc test zinc signal Research   Purple deficiency bacteria

36 BLOOD TEST ZINC DEFICIENCY
BLOOD TEST ZINC DEFICIENCY
Halo, thank you for visiting this url to find blood test zinc deficiency. I am hoping the information that appears may be useful to you









Zinc Deficiency Symptoms, Causes, Risk Factors, and More , Vegan Blood Test Results Blood Analysis B12 Vitamin D , Purple bacteria signal zinc deficiency Research , RBC Element Test DrJockers.com , Blood Metal Analysis MicroTrace Minerals , Celiac disease diagnosis algorithm , Is Your Thyroid Making You Tired No Matter How Much Sleep , Understand your blood test report , Heme: Red Blood Cells StudyBlue , Goat losing hair (no idea how to help her) Page 2 , Iron deficiency anemia pathogenesis and lab diagnosis , Poikilocytes Clinical Laboratory Science Vt131 with , Buy Solfe, Sodium Feredetate/ Iron/ Folic Acid/ Vitamin , blood test zinc deficiency,
Halo, thank you for visiting this url to find blood test zinc deficiency. I am hoping the information that appears may be useful to you

Belum ada Komentar untuk "36 BLOOD TEST ZINC DEFICIENCY"
Posting Komentar